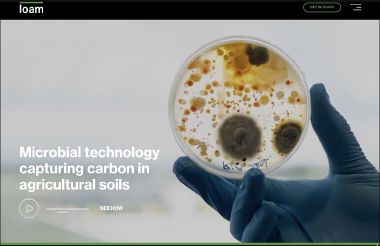

The Disenshittify Project
https://deshittify.us Disenshittify the Web one small step at a time. While the enshittification of the Web (and beyond) might seem far greater than any …

https://deshittify.us Disenshittify the Web one small step at a time. While the enshittification of the Web (and beyond) might seem far greater than any …

https://www.contxtu.al/dayahead Day Ahead provides a beautiful, glanceable overview of your calendar events for the day, so you can always see your next meeting …

https://www.jig.space Bring spatial computing to your interactive training and product demonstrations. With JigSpace for Apple Vision Pro you can explore and …

https://linktr.ee Everything you are. In one, simple link in bio. Linktree is a popular tool used by over 50 million people to organize and share their links …

https://supercut.vision Check out the enhanced versions of Netflix and Prime Video inside Supercut - Streaming Hub. Available for Apple Vision Pro on the …

https://crankyuncle.com The Cranky Uncle game uses cartoons and critical thinking to fight misinformation. The game was developed by University of Melbourne …

https://leonardo.ai Unleash your Creativity with the power of Leonardo Ai, Unveil new Creative Horizons with our Fine-tuned Models. Create production-quality …

https://badelmo.wtf “Bad Elmo” delves into the complex world of a Billionaire whose actions defy ethical standards, uncovering his personal behavior, breaking …

Profiles of the founders of Australian tech startups SafetyCulture, Canva, Finder, and Brighte. A look behind the scenes at the deep uncertainty, doubt, and …

https://www.bellabookings.com Bella Bookings - the easy way to manage appointments, staff and clients with salon management software tailored for barbers and …

https://footpath.ai Footpath.ai - Mapping the world for people Detailed sidewalk map data generated by our DeepWalk™ AI stack can be used for a range of …

The Big AI Mixer Pitches https://webdirections.org/ai/ Rapid fire introductions from Sydney AI startups: Nathaniel Kammer - contentable.ai Matthew Laird - Sahha …

https://sahha.ai Sahha - Create technologies that deliver better user experiences and healthier user engagements. Large social media and search engine companies …

https://www.contentable.ai Contentable.AI: Create Low-Code AI Models on Your Data, Fast. Create AI models in Minutes, not Months

https://www.skillojo.com Skillojo - Prevent hiring errors, delays, and costs Our mission: to empower employers to make better, quicker, and more cost- effective …

https://www.copydash.ai At Copydash.ai, we help businesses & brands create content 100x faster than other platforms & reduce your project costs by up to …

https://www.arbiter.technology Arbiter - transforming site security with autonomous surveillance robots.

https://www.artization.com Artization: Art iz in the eye of the beholder

https://www.stori.gg Stori.gg - Worldbuild like never before Create lore-consistent places characters, events, and items in seconds.

https://ai.socialrecommendator.com/ AI Social Recommendator - a recommendations generator for social and business network endorsements using ChatGPT.

https://www.rainbowroad.au/ Rainbow Road was created to help everyone make the most of World Pride Sydney 2023. It is an unofficial map collated from a variety …

https://goodteams.app/ Find an Australia-based Engineering team that fits your goals, skills, and values.

https://www.sublimemerge.com/ With a zippy cross-platform GUI toolkit, an unmatched syntax highlighting engine, and a custom high-performance Git reading …

https://www.spee3d.com/ We understand the challenges of manufacturing. Our mission is to make it easier. SPEE3D printers enable the most affordable metal …

https://www.themelt.io/ The Melt is everything you need to build innovative products and launch a great business. The Melt is an industrial prototyping lab and …

https://www.nurasound.com/ Nura designs headphones tuned to you. Bringing you closer to music with personalised sound.

In ‘The History of the Australian Startup Ecosystem’ podcast, join host Adam Spencer as they delve into the fascinating history of the Australian …

https://strongcompute.com/ At Strong Compute, we’re building the Future of Cloud, purpose built for AI that shapes the world.
https://www.loambio.com/ Microbial technology capturing carbon in agricultural soils. Loam is working to put agriculture at the forefront of addressing climate …

https://youpay.co/ With YouPay, you shop online and privately send your cart to another person with a single click using YouPay. Get the items you want and make …

https://employmenthero.com/ The smarter way to manage HR, people, payroll and productivity. For small and medium businesses on the up.

https://www.splashup.co/ At Splashup, we’re giving retailers the tools to simplify the way they engage with their customers for a more impactful, relevant and …

https://safewill.com/ At Safewill, we have helped thousands of Australians plan for and deal with their end-of-life – and we can help you too.

https://www.marli.io/ Marli make offsetting simple, easy and trusted. Using our infrastructure we make it possible for businesses and individuals to offset …

https://www.realar.com/ RealAR combines Augmented Reality and Artificial Intelligence to convert floor plans into walkthroughs that can be used onsite or …

http://farste.com/ The FARSTE MICRO was created by bikers who wanted something that goes further, faster, sexier and more comfortable than any narrow track …

https://www.ace-ev.com.au ACE EV offers a unique range of fully electric, light commercial vehicles and cars made for tradies and city living

https://ai.prompt.cards/ Be inspired to craft a perfect prompt with this 8-part questionnaire, filling out as much or as little information as you want, hit …

https://podandparcel.com Australia’s Tastiest, Sustainable Coffee Pods. Compostable & biodegradable coffee pods, ready to do good for the environment. …

https://sunbutteroceans.com.au Reducing, chemical sunscreen pollution with our reef safe and skin loving sunscreens. Bush and Sea inspired skincare

https://www.greenmyplate.com.au/ At Green My Plate, we’re supplying reusable, light-weight, plates, bowls & cutlery as well as wash stations, staff and …

https://www.samsaraeco.com/ At Samsara Eco, we’ve created plastic-eating super enzymes that break plastic back down to its core molecules regardless of colour …

https://kynd.com.au/ Find & Book the Right NDIS Support Workers. Kynd is about finding the right support in your local community. Your ideal NDIS Support …

https://findarat.com.au Helping you find those sneaky RATs.

https://returnrmarketplace.com Returnr is an environmental initiative aiming to eliminate single-use food and beverage packaging. Returnr marketplace is a …

https://www.sundrivesolar.com SunDrive is creating unique solutions to reduce the cost of high efficiency solar cells, whilst enhancing their performance and …

https://www.recyclesmart.com RecycleSmart is an innovative waste management company. We’re on a mission to make everyone recycle more. We believe recycling …

https://www.thefoundrycowork.com.au/ The Foundry Cowork in Erina is a shared workspace for freelancers, professionals and entrepreneurs wanting to escape the …

https://filma.app/ Filma: Pro, easy and fast video editor.

https://onlineornot.com/ OnlineOrNot is an independent website monitoring service, providing uptime checks, browser checks, and page speed monitoring. …

https://covidlive.com.au/ COVID Live data is collected from media releases and verified against state and federal health departments.

https://www.skedulo.com/ Skedulo makes mobile workforce management efficient and pain free — no matter what business you’re in.

https://www.projectf.com.au/ Project F helps companies achieve gender-diverse tech teams and supports tech women to achieve their career goals.

https://www.madpaws.com.au Find trusted, local Pet Sitters with Australia’s leading Pet Sitting Community.

https://www.humanitix.com/au/ Event ticketing that’s better. 100% of our profits fund education for disadvantaged kids.

https://pory.io Build membership apps and portals on top of Airtable without code.

https://goneutral.com.au Go Neutral makes it easy for everyone to take real, meaningful action on climate change. We’re starting with cars. We get it: you can’t …

https://towhomitshouldconcern.com/ Write a letter to a person who should be more concerned about climate change: our Prime Minister.

https://nextworldenterprises.com Next World is a virtual reality company helping induct and train employees safely and effectively through visually immersive …

https://bindimaps.com/ Bindi Maps, changing the way you navigate unfamiliar indoor spaces

https://www.screensizes.app Screen Sizes, a complete guide for Apple displays, by Toast Studio.

https://www.densediscovery.com A weekly newsletter helping you be productive, feel inspired, and think critically.

https://linktr.ee Connect audiences to all of your content with just one link. Linktree is the launchpad to your latest video, article, recipe, tour, store, …

https://inkl.com The world’s most important news, from 100+ trusted global sources, in one place. inkl is a mobile platform for good journalism. We bring news …

https://www.nexushub.com.au Nexus Business Hub is an agile co-working centre located on the Central Coast, NSW. Our building has been purpose built for you to …

https://www.ellumehealth.com We develop, manufacture, and commercialize the next generation of digitally enabled diagnostic products for healthcare …

https://www.nocodes.co/nca No-code Australia is a community made up of like-minded no-code enthusiasts. We all come from diverse backgrounds, are on different …
https://www.getmyagi.com Myagi gets the right information to the right people at the right time by digitizing the supply chain of knowledge for suppliers, …
https://cohortspace.com.au Centrally located in the Gold Coast, Cohort is a coworking and innovation space that is home to health and technology startups, …
https://goremote.com.au/ Discover the Best Remote Jobs in Australia GoRemote is the first dedicated remote work job board for Australia. Find and list …

https://lexer.io Drive marketing ROI, customer loyalty and revenue with Lexer’s customer data platform.

https://www.teaandbelle.com Téa&Belle is an Indigenous Gift-Ware Brand for all Australians. Téa&Belle has been established in the spirit of …

https://rtrspctv.me Inspired by an end-of-year twitter thread, an online annual Retrospective creator for personal or business use. By @halans

https://covid19nearme.com.au COVID-19 Near Me 2021 is an unofficial website based on open data (CC-BY) and other official sources, by @jxeeno.

https://www.covid19data.com.au This site brings together fragments of information and data that are technically but not practically available to the Australian …

Mandy Kerr of Fenders, talking at Web Directions Summit 2019.

Cheryl Gledhill, Head of Product at Blue Chilli Group, talking at Web Directions Summit 2019.

Build engaged, high-achieving teams by tapping into the powerful connection between engagement and performance, with CultureAmp.

KeystoneJS is an open source framework for developing database-driven websites, applications and APIs in Node.js. Built on Express and MongoDB.

A video game by House House. Available now on Nintendo Switch and home computers.

https://todo.vu todo.vu is a cool new productivity suite for small teams, freelancers, consultants. Most other tools only offer one feature and force you to …

Tim Lucas of Buildkite at Web Directions Summit 2018.

With the Australian Business Software Guide, our mission is to promote the top business software that is being created, right here in Australia.

HappyCo: Standardize inspections with consistent data capture for property conditions and achieve optimal compliance, faster turn and lower costs.

Fleet is in space! Our satellites make itpossible to connect IoT devices everywhere on Earth.

World Clock Pro Mobile, a great world time app to plan and organize through timezones.

Streamline user research and decide what to do next with Dovetail, cloud-based user research software you’ll love.

https://rightgif.com Find the right GIF, every time, with RightGIF.

http://peerism.org Peerism, the skill token economy for post-capitalism, solving the job automation and wealth inequality via a proof-of-skill blockchain …

https://www.everty.com.au Everty, a peer-to-peer electric vehicle charging network. Want to help other EV drivers navigate the city? Simply list your charger …

http://augmentspace.com http://augmentspace.com, the simplest platform to create virtual content or tours from scratch.

https://basiq.io Basiq is the best aggregation platform for acquiring financial data. We provide secure access to hundreds of financial institutions through a …

http://evergreen.com At Evergreen, we can secure the perfect domain name for your business.

https://www.recomazing.com Discover the best software and local services to grow your business with Recomazing, curated database of business recommendations.

https://www.spriggy.com.au Spriggy is a financial education offering for families built around a prepaid Visa card for 8-18 year olds with a purpose-built …

https://www.skymorials.com Whether you lost someone recently, or long ago, Skymorials helps you collect stories, tributes and memories from family & …

http://cxkit.co Easily listen to your customers and close the feedback loop with CxKit. Use direct customer feedback to drive your business and reduce churn.

http://nearsat.com NearSat is building a constellation of solar-powered drones that fly at 20KM above the Earth’s surface.

https://taskpigeon.co Task Pigeon is task management software that lets you track, manage and collaborate on your team’s everyday tasks with ease.

https://www.verbate.com Bring your research to life with video surveys using Verbate. Video insights from anyone – anywhere.

https://www.deputy.com Deputy, your complete staff management toolkit. Automate your workforce & spend time on things that matter.

https://premonition.io/ Premonition makes delivery and fleet management a breeze. Our powerful technology gives you full control, from route-optimisation and …

http://refinery.io Refinery, drag & drop online galleries in seconds.

Aubiz.net Aubiz.net was created in response to the expanding information market. We collected the data, analysed the databases and realised that a more …

https://qwilr.com With Qwilr, replace your PDF proposals, quotes and presentations with interactive & mobile-friendly webpages that plug into your systems …

https://slidebot.io SlideBot is the easiest and quickest way to create presentations. We know that creating powerful presentations takes up your time and …

http://www.become.education Become teaches kids age 10+ to explore, design and navigate their happiest possible future.

http://fuckrealestate.com Not keen on buying property at current prices? Yeah, F that.

http://folktale.io Folktale, a film director in your pocket. Our vision is to connect the world through stories.

https://www.upperstory.io Upperstory gives you the tools to validate your goals so you can focus on what’s important.

http://www.weployapp.com At Weploy, we’ve created a simple online platform that connects businesses looking for short term support staff with employees looking …

http://www.sourcr.com We believe Sourcr can be the missing piece in the recruitment puzzle. Providing a simple, user-friendly platform and excellent service to …

https://www.chug.com.au Chug is an online directory that allows you to search for food & drink specials happening at Melbourne’s most popular venues. With …

https://www.simpla.io Simpla isn’t an app, it’s an open ecosystem of content tools. Grab the pieces you need, create your own custom elements, build something …

http://workinc.com.au WorkInc is a place where good ideas come to grow; where the barriers for start-ups and growing businesses have been stripped away so that …

https://www.yqme.com.au YQme offers simple yet flexible online ordering for cafés, restaurants, pubs and takeaway food outlets. Connect with us today to see how …

The Burger Collective The Burger Collective dishes up service, rewards and social commentary that real burger enthusiasts can sink their teeth into.

http://hospitalglamour.com.au Hospital Glamour is a manufacturer and e-tailer of fashionable and practical hospital gowns for men and women.

https://www.foodbyus.com.au/ With Food By Us, discover great food from makers in your area. Order food from passionate nearby cooks at the touch of a button.

https://awe.media Awe makes 360 photos & videos truly interactive. Create & view VR/AR using your browser, on any device. No coding or app stores …

https://bountye.com/ Bountye is a mobile-only app for buying, selling and connecting with people you trust. For iOS and Android.

https://gotgastroagain.com/ Got Gastro helps you find potential food safety problems when eating out or buying food.

http://www.rapps.io/ Rappsio, a cloud framework for development teams. Build faster, without servers.

http://www.pokiefreepubs.com/ Pubs without poker machines. Seriously, how good are they? Pubs that focus on live music, or great food, or fancy drinks, or …

http://www.milanote.com/ Milanote, the notes app for creative work. For the research, thinking and planning behind your next great piece of work.

https://sonderdesign.com/ Sonder keyboard, infinite possibilities at your fingertips, world’s first E-Ink™ keyboard

http://www.zombie-anarchy.com/ Begin a desperate struggle to survive an apocalyptic world full of danger and opportunity. Gather skilled survivors to your side …

https://www.petcloud.com.au/ Petcloud, Australia’s most trusted pet sitting network. With local & national maps for searching, PetCloud makes it easy to …

http://lexy.io/ Lexy is working on one of the greatest challenges in AI and natural language processing. We are combining technology with human knowledge to …

VR Noir: A Day Before The Night by StartVR is an interactive crime thriller available on Samsung Gear VR and Google Cardboard (iOS & Android). Audiences are …

http://logline.it Logline It before spending months writing your story. This is not a contest, there are no prizes. All you get is some help from fellow writers …

http://www.buzzy.buzz Buzzy: communicate, coordinate and transact in one place, for Business Professionals, Sports Clubs and Team, Schools and Communities.

https://hireup.com.au Hireup is the easy alternative for Australians with disability to find, hire and manage their own support workers.

https://www.lawadvisor.com At LawAdvisor, we believe everyone deserves to understand, protect and enforce their legal rights.

http://www.lanewaylabs.com LanewayLabs is a Health Innovation Collaborative with a focus on Digital Health. The aim is to provide a catalytic framework to …

https://frontend.center Front End Center, screencasts on the web platform for web professionals.

http://www.squeakerdogs.com Squeaker, the ultimate in pet safety. Take back the night. Keep yourself and your pet safe with Squeaker’s Poochlight.

http://brewingcrate.com.au At Brewing Crate, we discover, research & share with you, the most incredible loose leaf tea available in Australia, crafted by …

http://www.clicklaw.com.au ClickLaw is Australia’s leading online law firm providing high quality legal services to clients online.

http://getcoworking.com.au At Sparro, we’ve recently opened up a small and affordable co-working space in our office located in the Sydney CBD. The shared …

https://www.goodthnx.me Good Thnx. Say thanks. Donate to charity. Feel good.

http://peakhourapp.com PeakHour. Monitor your Internet, WiFi and network performance, right from your menu bar.

http://www.zova.com Zova. Feel great everyday with achievable, personalised fitness.

http://www.goodspender.com.au At Good Spender, you buy directly from Australian social enterprises, businesses that exist to benefit the community. Make a …

http://www.kidsxap.com.au Kids Xap provides a single platform from which to manage your child care centre and ensure that it’s kept running smoothly. Childcare …

http://www.taskcity.com.au TaskCity is a Sydney-based Australian company which helps the community connect with each other and get things done fast and easy!

The Coterie is a co-working space designed to inspire entrepreneurial collaboration for creative professionals at QUT’s Creative Industries Precinc.

http://perf.email Perf.email, web performance tools, tips, talks and resources in your inbox.

http://votingchoices.com Voting Choices, learn more about the candidates in your electorate.

https://securecodewarrior.com Secure Code Warrior, an innovative and gamified approach to measuring and improving your secure coding skills.

http://www.blrt.com/ Blrt is an app that enables you to talk, point and draw over images, documents and websites.

http://bugwolf.com Rapidly audit the quality of your software, websites, and mobile apps with Bugwolf, where elite testers compete to make your products better.

http://joeycrowd.com Joey Crowd is disrupting the crowdfunding industry with a vision for new projects, investing, and a whole lot of sass.

http://aicial.com Aicial is a machine intelligent system that brings huge volumes of information in, interprets that information – and then provides educated …

http://www.marineverse.com MarineVerse, all about sailing in virtual reality.

http://tablo.io Tablo is everything you love about writing and reading in one place. It’s a home where writers can write, readers can read, and each can …

http://www.spotjobs.com SpotJobs connects relevant candidates to recruiters based on what they need, and makes it easy for job seekers to find jobs that suit …

https://au.oneshiftjobs.com/ OneShift is an online job network which matches employees with employers.

http://www.quberider.com At Quberider, we’re filling the void of engaging and integrated STEM education programs for our nation’s teens. We’re giving students …

Too Many Guns shows the extent of gun ownership across NSW.

https://SocialRecommendator.com Social Recommendator gives you a head start when writing an endorsement for a (ex-)colleague. Fill out some information on your …

http://www.videoslamapp.com VideoSlam finds your stories and throws them back at you at exhilarating speed. Shoot like you don’t have to edit. Get it on the App …

https://thedailyedited.com The Daily Edited is an online store stocking TDE, our eponymous line of personalisable leather goods, a collection of accessories …

https://cashper.me Cashper. Pay anyone.

http://brolly.com.au As social media engagement in government continues to grow, so does the need for a comprehensive approach to social media archiving, using …

https://revisit.io Revisit. Bookmarks, but better.

https://threadharvest.com.au Thread Harvest searches the globe for the most inspiring men’s & women’s fashion, each with a compelling story of social or …

https://piggymoney.com.au Teach kids about money in the real world.

http://austockphoto.com.au Austockphoto is an artistic community that supports photographers, designers, agencies and organisations by providing an archive of …

http://homeful.co At Homeful, we build you the tiny house of your dreams. And we find it a home.

http://www.skaterapp.com Skater, the skateboarding game every skater has been waiting for. Real skate spots, real skating feel, real gear. For iOS

BeeConnected BeeConnected, a world-first innovative communication tool to enable collaboration between farmers and beekeepers. For iOS and Android.

https://www.streat.com.au At Streat, we’d love you to come and share a meal in one of our cafes in Melbourne. 1 in 10 Australians will suffer from homelessness …

https://askizzy.org.au Ask Izzy, the A to Z directory of homeless help.

http://www.orangeskylaundry.com.au Orange Sky Laundry is Australia’s first mobile laundry service for the homeless. Our Vision is a world where people who are …

http://ompty.com Ompty will help you find an outstanding deal that suits your individual need.

http://zenthermostat.com Zen™ is a beautifully designed smart thermostat that allows you to control your home temperature from anywhere, anytime.

http://townske.com Townske, a simple city discovery tool with beautiful imagery.

https://clipchamp.com Clipchamp, share videos fast, record video easily.

http://www.unlockd.com Unlockd, changing the way people use and pay for their mobile phones.

http://biteable.com Biteable, world’s simplest video maker. Make animation completely online in minutes.

http://www.microburbs.com.au Microburbs, free reports with commute times, cafes, schools, neighbour demographics, noise, income and much more!

http://www.sideprojectors.com Sell, buy & discover side projects on SideProjectors and never leave your projects abandoned again.

http://urlsnap.io urlsnap.io is a fast and simple website screenshot service.

http://base.life We are Base. We create and invest in spaces and experiences to cultivate communities, culture and personal growth.

http://www.myxplor.com Meet Xplor, a complete childcare platform that’s simple, smart and occasionally magical.
http://localstories.info/ Let Australian stories come to you. We turned the ABC Local Story Archive of more than 8500 Australian stories into a Google Chrome …

http://www.crossyroad.com Crossy Road by Hipster Whale, an endless arcade hopper game.

http://thecluster.com.au The Cluster provides over 1600m² of office space with both coworking and private offices, venue spaces, beautiful boardrooms and …

http://www.floqapp.com Floq, gives you better tools to make professional surveys online.

http://www.funcaptcha.com FunCaptcha, putting an end to user frustration without compromising on security.

http://www.rubbers.co Rubbers, a simple service for students, couples, and cheeky people.

http://vinomofo.com It’s Vinomofo‘s mission to inspire the world to drink awesome wine. We only sell the wines we love and drink ourselves, so we know the wines …

http://www.thecommune.co COMMUNE is Sydney’s Inner West co-working space for creative industry freelancers, small businesses and entrepreneurs, located just off …

http://www.actcompanion.com ACT Companion, the ultimate acceptance and commitment therapy app based on the best-selling book, The Happiness Trap, by Dr Russ …

http://www.wotsoworkspace.com.au Wotso provides flexible workspaces ranging from private/group offices to open plan collaborative workspaces, group/project …

http://www.eatlove.com.au Eatlove, is a destination where food lovers can eat, cook and shop with inspiring chefs. Here you can expect to see some of your …

http://helloify.com Helloify is a simple website button that lets you message and live chat with your visitors. You can set it up for free in under 60 seconds, …

http://omnyapp.com Omny lets you create a personalised radio station with only the radio shows, music and podcasts you love.

http://www.offscreenmag.com Offscreen, an independent print magazine about the people behind bits and pixels.

http://www.themoderndesk.com The Modern Desk, a fine selection of apps and accessories for the modern office, straight to your inbox once a week. By the …

http://spotcard.co Spotcard helps you maximise the networking potential of LinkedIn. Make new connections with LinkedIn members nearby.

http://spacecubed.com Spacecubed, a 1000 square metre entrepreneurial hub in the heart of the Perth CBD, where teams and individuals can grow their businesses …

http://grindcollective.com The Grind Collective delivers a service that provides up-to-date trading hours for specialty coffee shops (including regular and …

http://www.mindfulinmay.org Be Mindful In May. Join the 10 minute a day global mindfulness meditation challenge. Receive guided meditations and interviews with …

http://www.makersplace.org.au Makers Place consists of like-minded people who are passionate about innovating, creating and collaborating. We provide access to …

http://www.workclub.com.au For entrepreneurs and business leaders, Work Club is the global platform to connect, collaborate, learn and explore.

http://squiddies.tv Flip Reel by Squiddies is a modern take on the ancient art of hand line fishing. Flip Reel makes it safe and easy for you and the kids to …

http://www.cultureamp.com Culture Amp, the survey platform for people & culture. Culture Amp takes running an employee survey and combines it with a great …

http://webcred.it/ Webcred.it, it’s IMDb for the internet. Finally tell the world what you really do.

https://www.pethomestay.com.au Find trusted, local pet sitters on PetHomeStay. Cuddles, walks, and playtime are included with PetHomeStay. Your pet is treated …

http://radalert.io RadAlert, monitoring for people who don’t do monitoring.

http://foundedinaustralia.com.au Part of the FoundedX community, Founded in Australia is a tribute to innovative startups that are proud of their Australian …

http://crepesforchange.com At Crêpes for Change, we are going to create a social enterprise in the form of a crêpe van roaming Victoria’s streets, markets and …

http://easyresapp.com EasyRes is a fast screen resolution switcher for Mac OS X with live animated previews. Quickly and easily choose between Retina and …

Harken Harken, a beautiful yet simple music player for your iPhone or iPod that uses gestures to control music and podcast playback. For iOS.

http://gifwrapped.co GIFwrapped, the iOS app for collecting and sharing GIFs right from your iPhone or iPad.

Numerical Numerical is the calculator without equal. Whether you’re doing simple math, advanced brackets or need a running history, Numerical has the answer! …

http://www.signonsite.com.au SignOnSite site register platform, an innovative workplace safety app.

http://samplecoffee.com.au Subscribe to the Sample Coffee Brew Crew and get coffee perfectly roasted for filter delivered fresh to your door anywhere in …

http://buildkite.com Buildkite. Automate your team’s software development processes, from testing through to delivery, no matter the language, environment or …

http://limerocket.com LimeRocket, crowd games for venues.

http://farmbot.com.au FarmBot is an easy to install and easy to use, inexpensive sensor service for farms and remote environments. Our technology will allow you …

icentral.co iCentral coworking space for tech startups, 2 mins walk from Town Hall Station with an 250 square metre sunny dedicated outdoor area, showers

ShipYourEnemiesGlitter.com Glitter as a Service: want to piss off someone you dislike for only $9.99? Let us send them some stupid fucking glitter that is …
http://www.podtrackers.com Pod Trackers, the World’s smallest and lightest fully waterproof GPS pet tracker. Never lose your pet again.

http://www.thevoxelagents.com The Voxel Agents are developers of original hand-crafted games for “on-the-go” fun times. They are an independent team with five …

https://sitthetest.com At Sit the Test, we created an easy way for you to take tests that prove your skills as a developer.

http://true.wearebrightly.com True is a song about finding your place in the universe. It is taken from our forthcoming record, Oh, Infinity. If you pre-order …

http://thewholepantryapp.com Here at The Whole Pantry, we believe in living your whole life, so we created the world’s first health, wellness and lifestyle app …

http://www.villageaustralia.com.au Village North Sydney, a coworking place to connect, create and collaborate.

http://www.gyde.tv Gyde is built to do one thing; help you quickly and painlessly explore movies to find something you want to watch. By @sutto.

http://www.tworagsclothing.com Two Rags, underwear with a mission. For every underwear purchased, we give a kit of eco-friendly sanitary pads to a woman in …

http://www.societyone.com.au SocietyOne is a whole new way to borrow and invest. We connect quality borrowers with savvy investors, reducing the cost and …

http://www.wattcost.com Wattcost is a revolutionary new energy saving technology which magically puts the power back in your hands, with real-time control of …

http://chainyjs.org/ Chainy is a chainable data pipeline for JavaScript, it’s like jQuery but for data. It has built-in support for error handling, flow …

Stopover Stopover connects like-minded people in airports. Try Airport Dating, learn a new language, meet other travelers or expand your business network. …

http://www.minutely.com Minutely, a fun approach to a serious weather problem. Contribute to a totally new crowdsourced weather model that with your help will …

http://echohealth.co Echo is a wearable device to help epilepsy sufferers manage medication, predict potential seizures and alert emergency contacts in the …

http://swiftly.com Swiftly makes it super simple to get any small design task done quickly. From logo improvements, to business card updates, or even photo …

http://gofar.co GoFar, understand your car better and reap the rewards in smarter, safer, cheaper driving. You always know the full cost of a trip in taxis, …

http://getvinus.com Vinus recognises any wine from a photo. Remembering, sharing, discovering and buying amazing wines has never been easier. Simply take a …

http://www.beingwhimsical.com Being Whimsical offers several ranges of greeting cards from whimsically colourful pretty girls through to inspiring quotes, and …

http://www.sendle.com Sendle is out to bring the postal service into the 21st century. Sendle utilises the power of established courier networks to enable you …

http://oxfordfoundry.net Oxford Foundry, an open plan collaborative co-working space designed specifically to suit the needs of established and start-up …

http://www.bodywiseapp.com Track more than just steps and sleep. Use BodyWise and sync your Fitbit or Jawbone UP (optional) and do more interesting and …

http://www.oranparksmartworkhub.com.au The Oran Park Smart Work Hub provides a professional working environment for commuters and small businesses with …

http://bellabeat.com.au Track the most important experience in your life, with BellaBeat. Track your baby’s movement & keep a Kick counter chart. Download …

http://smalltoday.com With Small Today, grow your business with a community of your peers. Build your circle of influence and benefit from the network. Take …

http://mybespokechair.com My Bespoke Chair loves chairs! We give you the design tools to create your perfect chair, handcrafted by our master upholsterers in …

http://www.nextforsale.com.au Why can’t buyers be alerted by home owners that a property is coming up for sale soon? Get the inside scoop on what properties are …

https://atmail.com Atmail lightweight & rock-solid linux based email, calendar and contacts, powering over 40 million paid mailboxes in 123 countries. …
![Albums (feat. Louie Mantia) [Radio Edit]](https://madewithlove.in/orig-content/uploads/2014/08/Albums.jpeg)
http://albums.pink Listening to music shouldn’t be complicated. So we created Albums for iOS, with a spot for your favorites and a handy search field for …

https://qwilr.com Using Qwilr‘s visual quoting tool, beautiful quotes and proposals are delivered as webpages and work seamlessly across desktop, tablet and …

http://prevue.it Prevue is a design sharing tool for agencies, designers and creative professionals.

http://web-design-weekly.com Web Design Weekly, a once a week email with no spam, no rambling. Just pure awesome links to the best news and articles to hit the …

http://www.nerdherd.gg NerdHerd is a social media network built to connect gamers who live close to each other and share the same passion for gaming.

http://www.ridesurfing.com Ridesurfing is a growing community that allows people wanting to travel locally, to connect with fellow members willing to give them …

http://www.nexusnotes.com With Nexus Notes, Australia’s #1 marketplace for students notes, cash in all your hard work and earn money every time your lecture …

https://www.shoeboxed.com.au Shoeboxed scans and organises your receipts, invoices and documents securely online. Shoeboxed extracts the data from the pages and …

http://bugherd.com BugHerd is a visual bug tracking and project management app built for web developers and designers. It lets you report issues directly on a …

http://www.getstack.io At a glance Stack has a fully customisable task board, providing end-to-end task and workflow management. Users can create and customise …

https://www.parentpaperwork.com ParentPaperwork is an online tool to capture parent permissions and responses for their kids’ activities. ParentPaperwork …

http://gyde.tv Gyde.tv helps you quickly and painlessly explore movies to find something you want to watch.

http://www.lumific.com Lumific, your smart photo assistant. Photos intelligently organized, beautifully enhanced.

http://www.crewwith.me At Crew With Me, we match keen crew to owners for the day. View and sign up for boating events today. Find experienced crew for your next …

https://www.tushare.com TuShare is an online marketplace where every item is free. We believe in generosity and gratitude, so you can join the community and …

http://www.metrocide.com Metrocide, a relentless stealth-action game where the whole city wants you dead. Duck and weave through the claustrophobic streets and …

http://revealapp.com Reveal brings the power of tools like Firebug and Web Inspector to iOS developers. Reveal makes complex applications easier to understand.

http://fatmumslim.com.au The Little Moments App by Fat Mum Slim, brings you two apps in one: a super fun photo editor, as well as the perfect Photo A Day …

http://solidifier.com.au Solidifier, Australia’s first hardware makerspace – co-working community for the Kickstarter generation in Sydney.

http://burbia.com.au BURBIA is all about creating beautiful affordable suburban typographic screen prints of the places we live and love. Working our way across …

http://www.brolly.mobi Brolly tells you when it’s going to rain on you. Brolly sees an hour or two into the future so you can grab your umbrella or feel safe …

http://vame.me Vame. Voice your Name. Record the personal pronunciation of your own name and add it to your email signature and online profiles.

http://www.studio410.com.au Studio 4.10 is a Sydney-based (Rosebery) professional photography studio offering an affordable studio hire for photographers.

http://www.tzukuri.com Tzukuri, the new industry standard in eyewear. Never lose your eyewear, or your phone, with the embedded custom designed beacons into …

My Opal lets you keep an eye on your Opal card balance and journey history. Manage your Opal Card on the go from your iPhone or Android smartphone.

Sydney Trains Coffee Map was researched, designed and developed by one of Sydney’s (self confessed) coffee snobs as a means of suggesting the best cafe for each …

http://www.swarmmer.com Swarmmer, rethink music intelligence. Join us as we look to infuse some humanity into music discovery

http://www.couchelo.com Couchelo is a curated marketplace for unique furniture and homewares. Design lovers – find hundreds of cool items from boutique sellers, …

http://www.origrami.com At Origrami, we create thoughtfully designed and lovingly crafted Instagram print. We print all our photographs in Sydney, Australia …

http://redpen.io Red Pen, the fastest feedback tool for visual teams. No matter where your colleagues are in the world, if you work with visuals we’ll help you …

Put a mini map on your Pebble smart watch, and get turn-by-turn directions to a destination with PebbGPS by Nathan Oates. For iOS.

http://getcomposure.com Composure completes you. It provides text completion suggestions while you type, and it fetches the important stuff you’ll need before …

http://www.99interns.com 99 Interns connects students and interns who want and need experience to startups and other cool businesses.

http://www.solididea.com Solid Idea‘s ChocaByte. Introducing the worlds first affordable personalized chocolate 3D printer that allows you to express your …

http://www.friendlydogcollars.com.au Friendly Dog Collars‘ unique range of colour coded dog collars, leads and harnesses are helping responsible dog owners all …

http://oz-player.com OzPlayer, the first completely accessible video player, fully compliant with the W3C Web Content Accessibility Guidelines, Version 2.0, …

http://newportnet.com.au NewportNet, your office when you want it. The Northern Beaches of Sydney is not only a great place to live, but full of talented people …

http://ohiosurryhills.com.au OHIO Surry Hills, an inspired coworking space overlooking Sydney’s Harmony Park, complete with Herman Miller furniture, and …

http://entry29.org.au Entry 29, Canberra’s community coworking space where entrepreneurs connect, create, and collaborate. Coworking can boost your productivity …

http://manlyemporium.com Manly Emporium, a stylish new co-working space, located in the centre of Manly. A collaborative environment of the most innovative and …

http://wearableexperiments.com Wearable Experiments (We:eX) is a socially driven wearable technology company. Our mission is to bring together fashion and …

http://www.my-puppy-training.com Sound Proof Puppy Training, by qualified dog trainer Amy Smith, assists you getting your puppy comfortable around environmental …

http://omnyapp.com Omny, the personal radio app that plays only your favourite shows. Stay updated on technology, business, entertainment and more with all of …

http://www.sublimetext.com Sublime Text is a sophisticated text editor for code, markup and prose. You’ll love the slick user interface, extraordinary features …

http://bitrocket.co BitRocket, Bitcoin made easy. No risky and complex dealings with foreign exchanges or bank wire fees. We connect you to the best Bitcoin …

http://loopyapp.com Loopy by A Tasty App, a savvy, sophisticated, tactile looper that reinvents the formula. Make music on your iPad or iPhone from anything. As …

http://www.bikebuddies.net.au At Bike Buddies, we want to share the thrill of getting around by bike. It’s fun, energizing, healthy and can be amazingly …

http://www.pixcapp.com Our mission at Pixc is to turn your product images into awesome ones so you can increase your online sales. Great photos can increase …

http://hubsydney.com HUB Sydney is not just any shared work space, it’s designed to be your space. We accommodate a variety of work styles from open and …

http://www.setmyscene.com Set My Scene makes finding the right venue for a date in Sydney simple and fast.

http://www.keepsydneyopen.com Keep Sydney Open, by the Sydney Late Night Culture Alliance. We are a group of cultural bodies, businesses and artists, and …

http://localpush.com.au Local Push is a celebration of the some of the amazing things Sydney has to offer. Sometimes great talent goes unnoticed and …

http://www.coinjar.com CoinJar is your Bitcoin wallet on the go. The secure, user-friendly and beautiful cloud wallet for digital payments.

http://www.duetgame.com Duet is a game that asks players simply to navigate two orbiting spheres past an increasingly complex maze of falling obstacles. Duet is …

http://www.elto.com Elto helps to connect small business owners to the best web developers and marketers from all around the world.

http://www.opalornot.com Opal or Not? Find out if Sydney’s new transport smartcard will cost you more.

http://milliondollarbeard.com MillionDollarBeard, a rare and momentous opportunity to own the world’s first #milliondollarbeard, and support a movement which …

http://shootthedog.com.au Shoot The Dog, is a unique fundraising initiative for rescue animals here in Australia, raising funds for Maggie’s Rescue.

http://oceanswims.com Ocean Swims, the home of fine ocean swimmers.

http://www.vandaltrak.com.au VandalTrak, for a cleaner and safer community. Record and report incidents directly onto VandalTrak’s graffiti management system. …

http://www.clueyvoter.com Cluey Voter makes it easy to vote “below the line” to really make your vote count.

http://abbottisms.com/ Abbottisms (quotes by Tony Abbott).

http://sorryasylumseekers.com Sorry Asylum Seekers is about humanity and compassion, where everyday Australians embarrassed about how asylum seekers are treated …

http://www.canva.com Canva, a simple new way to design. Canva makes it easy to create professional designs and to share or print them. Canva gives you …

http://shotkit.com ShotKit, a peek inside the camera bags of professional photographers.

http://consciousstep.com Conscious Step gives an ordinary purchase, extraordinary purpose. Socks that fight hunger. Conscious Step begun as the idea that an …

http://www.openlearning.com At OpenLearning, our mission is to give you the freedom and the flexibility to form a community, express your creativity and …

Decoys of Me uses historical and geographic data to randomly create realistic-looking and entirely fictional characters, by @leslienassar For iOS.

http://www.sydneystoryfactory.org.au The Sydney Story Factory is a not-for-profit creative writing centre for young people in Redfern, Sydney. Our volunteer …

http://permaling.com Permaling helps organisations implement sustainable IT through informed decisions. Search for products meeting criteria on efficiency, …

http://comparesuper.info CompareSuper, a micro site for comparing AU supers by @rufuspost.

http://fauxial.com Fauxial, random faux social media profile generation.

http://patcht.com/ Patcht gets users involved in the creation process of their own garments. We offer a huge range of garment cut/colour and patch combinations, …

http://cutefru.it Cute Fruit, the cutest way to track your baby’s growth! Cute Fruit is for expecting parents. Learn how big your baby is each week. Free, on …

http://christmasconversations.com.au (Last days to) Share your own message of light and laughter with Christmas Conversations — and paint it with your own …

http://mentortrak.com At MentorTrak, we connect students with experienced mentors and help them start conversations about their careers.

http://haveibeenpwned.com ‘;–have i been pwned?, check if you have an account that has been compromised in a data breach.

http://rbutr.com rbutr tells you when the webpage you are viewing has been disputed, rebutted or contradicted elsewhere on the internet.

http://theveganteahouse.com The Vegan Teahouse is proud to introduce a family of extra tasty, cruelty-free treats and beautiful loose leaf teas.

http://www.botbitz.com BotBitz, your one stop shop for Combat Robot parts in Australia.

http://swdufanfilm.com/ Star Wars Downunder, is a 30 minute Star Wars fan film by Michael Cox which finally answers the age old question, that has confounded …

http://www.sorrythanksiloveyou.com Sorry Thanks I Love You is about reigniting the culture of giving. Because your people are important and giving is one of the …

http://www.bluedot.com.au Bluedot Innovation specialises in high precision location-based services and payments.

http://thevtalkphone.com At last, a desk phone as good looking and as easy to use as a smartphone. The vtalk phone reinvents what a desk phone is. Pre-order on …

http://www.swatchmate.com SwatchMate Cube, capture the color of any surface. Place the Cube onto a surface and it will instantly capture its color, displaying …

http://picturepostie.com.au Picture Postie, quality photo and canvas prints from your iPhone, Instagram, Facebook and Flickr accounts delivered straight to your …

http://startupgroovy.com StartUp Groovy, startup accommodation and co-working space. We help entrepreneurs turn their ideas into a business!

http://newsmaven.co With NewsMaven, help your readers see the content they want. Surface relevant content for your users. Put NewsMaven to work for your site or …

http://www.fastmail.fm Fast, reliable email for businesses, families and professionals. Reliable, private and secure, FastMail has no ads, excellent spam …

http://cofoundercrush.com CofounderCrush. Are you my perfect (cofounder) match? Potential tech cofounders (ladies & gents) wanted!

https://shoutforgood.com Shout is an App based, micro donation platform designed to raise funds for organisations in a fun, simple to use and socially connected …

http://thefetch.com The Fetch is the gateway to your city, career and local community. The Fetch enables everyone to discover, enjoy and love what they do. We …

http://holiday.moorescloud.com Holiday, the world’s smartest Christmas lights. Holiday by MooresCloud is the world’s first connected, intelligent, beautiful and …

http://www.thecookapp.com Cook is your very own Cookbook for iPad, use it to share the food and recipes you love with family and friends. By Apps Perhaps in …

https://weteachme.com WeTeachMe is Australia’s first trusted community marketplace to list, discover and book in-person courses. For course providers, we help …

TripView displays Sydney Train/Bus/Ferry timetable data on your phone. It features a summary view showing your next services, as well as a full timetable …

http://lovely.io Lovely.IO is a front-side development platform, which includes a modular framework, development tools, CDN hosting, packaging and asynchronous …

https://lisant.io Lisant, bookmarking & feed reading. By @julio_ody.

http://www.musomap.com Musomap is The Global Map for Musicians. It helps musicians find a teacher, start a group, promote their music, share a gig and trade …

http://clarity.io At Clarity, we follow the lead of the smartest givers. We are developing a minimally intrusive evaluation system for promising charities here …

http://www.beanhunter.com Beanhunter makes it easy to find and share your coffee experiences. It is a door into a city’s coffee culture. You get in and get to …

http://lawpath.com.au Lawpath, legal help made easy. Speak to a lawyer for free. Get help with your legal questions on a 30 minute phone call with a lawyer …

http://www.bigdecisionsapp.com Big Decisions, the personal decision assistant for iPad. Whether you’re buying a house or an apartment, a new car, phone or …

https://sideracket.com Side Racket connects people and projects so you can do more of what you love. More side projects, more awesome to make the world better.

http://foxglovelettering.com Foxglove Lettering is a boutique lettering and design studio run by Carla Hackett (@canarycarla). Foxglove (@foxgloveletters) is …

http://www.projecttripod.com Project Tripod is new app (in development) that allows you to track anything you’d like over time by letting you take the exact …

Quick Maths Practice your mathematics while racing the clock in this innovative iOS app. Featuring advanced handwriting recognition and a beautiful interface, …

http://www.electionleaflets.org.au Election leaflets are one of the main weapons in the fight for votes in Australia. They are targeted, effective and sometimes …

https://www.openaustraliafoundation.org.au The OpenAustralia Foundation is a pioneering charity whose vision is to transform democracy in Australia. Our mission …

http://1disease.org One Disease at a Time is a non-profit organisation that has a simple but groundbreaking vision: to systematically target and eliminate one …

http://pressselectpublishing.com Press Select is an independent publisher specialising in original and unique approaches to long-form videogame criticism …

Pocket Words Pocket Words is a fully featured word puzzle game from Shiny Things. Sharpen your mind with these addictive challenges and enjoy seven different …

Rain? You’re in Australia? You want to know if it’s going to rain?. You want to know quickly, because you’re too busy, or you want to use that new/old …

http://www.truefoodsnutrition.com.au At True Foods Nutrition, our aim is to promote traditional foods that have nourished our ancestors for millions of years …

http://www.wooboard.com WooBoard, a simple and elegant solution to boost recognition in your workplace. We believe your employees deserve to be recognized for …

https://getpocketbook.com Pocketbook makes personal finance ridiculously simple.

http://citytag.com.au CityTag is designed to help you find the best info about town, local to where you are – on the spot! Restaurants, public toilets, special …

http://helpa.com Helpa creates a way for you to have a personalized Internet experience based on your own choices that asks you what you want, listens to what …

http://venuemob.com.au Venuemob makes it super simple to find, compare and book function venues for your next event. We are a young team that loves to hunt down …

http://perspectivecorrect.com Perspective Correct, for iOS, is an easy and accurate way to fix the perspective of your photos. Perspective Correct adjusts …

https://www.payly.co Payly allows anyone to accept payments simply and easily by creating payment pages, hassle free.

http://issue.by Issue is taking brand & style publishing to the next level. Finally, editorial content, rich media and curated shopping content from your …

http://www.thespecialsboard.com.au The Specials Board. Get exclusive, local offers from bars, cafes and restaurants on your smartphone (iOS, Android, OVI).

http://teachforaustralia.org Teach for Australia is an ambitious social movement working to confront educational disadvantage in Australia.

http://www.adventurehoney.com AdventureHoney was created to help people find kick-arse adventures provided by awesome operators. But, it was inspired with a …

http://www.joebutton.com Joe Button, create your own European cotton dress shirt and have it tailored to your exact measurements for a perfect fit. At Joe …

http://www.scrambledapp.com Scrambled, the game that flexes your mental muscles by unscrambling 9-letter words. For iOS.

Penbo time capsule gives you the chance to make your mark in the ageless and infinite eternity, that is space! Penbo Timecapsule is your chance to have your …

Next Manly Ferry Next Manly Ferry is your easy, reliable and up-to-date way of checking when the next ferry is leaving to or from Manly in one of the 3 major …

http://picster.me Picster, create tailor made albums in minutes, using backgrounds, frames & corners to help enhance the story of your album. For iOS.

http://curvy-world.com CURVY is a platform where the latest generation of female creative talent can shine. CURVY began as an annual book and exhibition series …

http://www.goodreturn.org At Good Return, we connect Australians to the working poor in the Asia Pacific who need a small loan to start or expand a small …

http://www.acitywithquirk.com.au A City With Quirk is an online hub for listing, exploring and connecting with Activities, Events and Experiences in eclectic …

http://www.wattcost.com Wattcost makes households the smartest energy consumers on the planet. The Wattcost “beacon” is a beacon of hope for Australians worried …

http://theofficespace.com.au The Office Space is a unique boutique office and multifunctional space that stands out amongst more homogenous working …

http://www.paperradio.net Paper Radio is an audio journal, that takes stories by Antipodean writers and fuses them into a unique alloy of narrative, sound …

http://dumbwaystodie.com So many Dumb Ways to Die, by Melbourne’s Metro Trains.

http://rubbe.rs Rubbe.rs, a simple service for students, couples, and cheeky people. Condoms delivered monthly. We give 50% of our profits to help combat sex …

http://www.growitlocal.com.au Grow it Local launched in March 2012 as a pilot project in Waverley Council to celebrate and encourage backyard, balcony, …

http://www.theloop.com.au The Loop, Australia’s largest professional creative community. At The Loop, we’re connecting creatives with companies, collaborators …

http://bugcrowd.com Bugcrowd is by far the most comprehensive and cost-effective way to secure websites and mobile apps. Win Cash and Kudos for being the first …

http://okcofounder.com Hey, my name’s Anthony and I don’t have a co-founder. Is it you?

http://puppytales.com.au Puppy Tales is the perfect place to find articles about caring for and enjoying life with your dog. From cute photos, advice on dog …

http://www.giggedin.com GiggedIn, by Edwin Onggo, a die hard music fan and wannabe producer. GiggedIn enables you to book events with a guaranteed audience. …

http://www.redbubble.com Redbubble is quite simply the finest and most diverse creative community and marketplace on the interlink. With artists and designers …

http://garagesaletrail.com.au Garage Sale Trail is a national, people-powered program that’s about sustainability, creativity and fun. Garage Sale Trail enables …

http://www.localharvest.org.au Local Harvest is a community project, initiated by the Ethical Consumer Group, with a view to providing a resource to make it …

http://www.roomz.com At Roomz, we’re creating a better way to find awesome roommates – and take the stress out of shared living. We are focusing on the people …

http://www.vimily.com Vimily, social branded videos. Film and share all the excitement and fun at your event. Interview your attendants about your bar opening, …

http://www.airtasker.com Airtasker. Find people to help you around the home and office. We provide an on-demand workforce for your business and marketing …

Kosciuszko Huts Map by Narelle Irvine, a GIS specialist. Narelle and her family have been involved with the Kosciuszko Huts Association – who maintains the old …

http://www.kinderloop.com Kinderloop, a web and mobile communication app that connects child carers and parents worldwide. Carers use kinderloop to quickly and …

http://www.leagueofgeeks.com League of Geeks is an indie game development collective comprising talented professionals from video game development and multiple …

http://www.robot-circus.com Robot Circus are a passionate creative team, with a wealth of experience in games development. We love gaming and story-telling, and …

http://delimiter.com.au At Delimiter we’re passionate about just two things: Technology and Australia. We exclusively cover the local technology sector — …

http://tinybeans.com Tinybeans enables even the busiest of parents to create a beautiful online journal of their children’s lives to share with close friends …

The Vibewire Innovation Lab is a community where skills, resources and networks are shared between its members. Events, skill-building workshops and networking …

http://www.yourdesk.com.au Within walking distance to bars, restaurants, boutique stores, grocers and transport and some of the best coffee in Sydney, Your Desk …

http://kickfolio.com Kickfolio. Promote your apps, discover new users & engage your audience with an interactive app demo. Increase your app conversions, …

The OpenHub on Collins Street is a workspace where creative professionals and business owners can come and work in the City of Melbourne at an affordable price. …

http://www.spark.org.au Spark* enables local Changemakers in some of the poorest places on the planet. The Changemakers stay connected to the Spark* team and …

http://www.effectivemeasure.com Effective Measure. We are a bunch of really curious people, looking to form communities with others who are just as inquisitive. …

Bespoke.js, a DIY presentation micro-framework by Mark Dalgleish. Bespoke.js provides the foundation, then gets out of your way so you can focus on uniquely …

http://earl.io earl checks your web site on smartphone, tablet and desktop devices every day and notifies you when something looks wrong, protecting your brand …

http://kickingthecan.org.au Kicking The Can, 266 bottles and cans are littered or landfilled every second in Australia alone. Be part of the solution. Every …

http://www.carnextdoor.com.au Car Next Door is the first car-sharing service of its kind in Australia. It gives you access to the car you want, when and where …

http://www.jayride.com.au Travel A to B with Jayride. Find unique, cheap and fun land transport. Make money towards costs every time you drive. Find unique …

http://www.openshed.com.au Open Shed, share to access what you need and help your neighbours. Tools, camping gear, electronics and everything in between. Open …

http://www.startnest.com StartNest is a coworking space for technology focused businesses and freelancers in Sydney’s North Shore, located in Crows Nest/St …

http://zookal.com Zookal, making students’ lives easier. Zookal is a mysterious place where students can come to buy and rent textbooks. Students can also make …

http://envato.com Envato‘s mission is to help people to earn and to learn, online. We operate marketplaces where hundreds of thousands of people buy and sell …

http://www.peazie.com Peazie, social media made easy. Our simple plug and play tools make it easy Peazie for you to run engaging and interactive campaigns.

http://beginnings.wearebrightly.com/ Brightly made an album, called Beginnings & Endings. They wanted people to share it – to send it to their friends and …

http://www.tankstreamlabs.com Tank Stream Labs is a co-working & entrepreneur community located in the heart of Sydney’s CBD. We offer an inspiring work …

http://homeworksyd.com.au Homework is a coworking place for the business nomad or virtual employee. We’re located on the busy and eclectic Oxford St on the …

http://houseof.co The House of Commons Digital Co-Working Space is a newly converted 140 m2 red brick warehouse. Initiated with the sole purpose of providing a …

http://www.reasonwell.com ReasonWell helps people to engage in productive debate, by making it easy to map out arguments, assumptions and evidence. You’ll be …

http://whogivesacrap.org Who Gives A Crap! We started Who Gives A Crap when we learnt that 2.5 billion people across the world don’t have access to a toilet …

Water Storage, the Bureau of Meteorology’s official Water Storage application for iPhone, by Icelab. Find how much water is available in Australia, your state, …

http://uxmastery.com UX Mastery is an online resource for aspiring user experience designers.

http://www.unoil.com.au Uncommon company, U fuses performance ecology materials, best practice manufacturing and brightest creative minds to unlock game …

http://www.weco.com.au WeCo co-working space. WeCo is a purpose built coworking space for start-ups, entrepreneurs and independent workers to get out of a …

http://newsmodo.com Newsmodo. Designed by journalists, Newsmodo is a revolutionary platform that allows media professionals to source or sell newsworthy content …

http://decafsucks.com Decaf Sucks! There’s a lot of coffee out there. We want to help you find the good and avoid the bad. Life’s too short to drink bad coffee.

http://www.textiletheory.com Textile Theory is passionate about natural and organic fabrics – luxurious textiles that are produced with artistic flair and …

http://www.clipp.co Clipp, Tabs made easy. Open. Share. Pay. With Clipp, you’re always in control. You can set a limit as to how much you want to spend each …

http://trickleapp.com Trickle is a passive Twitter client. Simply launch Trickle and let it do its thing. Tweets are displayed individually so they are easy to …

Forte by Jake MacMullin (Stripy Sock) presents the National Library of Australia’s collection of digitised sheet music, more than 13,000 individual items – your …

Associate Creative Director, channeling the accumulated wisdom of the industry at large, just shake your phone to see the end of any argument, for iOS.

http://fromlittlethings.co From Little Things (FLT), an industry news source and an ongoing series of events. FLT is our attempt to change the perception of the …

Journey Planner VIC, a free Melbourne train, tram and bus journey planner / timetable app for Windows Phone 8. Simply enter your origin, destination and …

627.AM is an attractive and intuitive daily assistant for Windows Phone 8. It includes a wake-up alarm, as well as the daily temperature forecast, and the …

http://tinmangames.com.au Tin Man Games is a video games studio based in Melbourne.

http://www.whistleout.com.au WhistleOut, we built technology to help you make a good decision. Compare mobile phones & plans, broadband plans, credit cards, …

http://surftourist.com Surftourist was an itch that the two surfers, Dylan Fogarty-MacDonald and Ben Webster, wanted to scratch to share your surf trips and …

http://www.enginerm.com EngineRoom is the co-working space for digital services businesses and freelancers. Born out of the work started with Fishburners, we’re …

http://lifx.co LIFX, the light bulb, reinvented. A wi-fi enabled, multi-color, energy efficient LED light bulb that you control with your smartphone. Integrate …

https://teamstuff.com With Teamstuff on web & mobile, your team stays connected. No more admin dramas for coaches & managers. No more scheduling …

http://goodfil.ms Rate, review, and share films with your friends on GoodFilms. Find new movies to watch based on you and your friends’ taste.

http://posse.com Posse helps you find all the best places in the world according to people whose tastes you can trust – your friends.

http://mythofme.com Write your life story one question at a time. MythofMe deals with personal stories, autobiographies. Our mission is to make it possible for …

http://www.yiyinglu.com Yiying is a Sydney-based illustrator, graphic designer and art director. “Yiying” is 2 characters in Chinese. “Yi” means happy; “Ying” …

http://www.collaborativeconsumption.com/ Collaborative Consumption, sharing reinvented through technology. Together, entire communities and cities around the …

http://www.pygg.co Pygg, cashless payments designed for schools. Pay for the canteen, excursions or other events online or on your mobile. No more crumpled late …

Oz Weather. All the essential Australian weather information you need in the palm of your hand – presented quickly, clearly and elegantly.

http://www.campaignmonitor.com Campaign Monitor makes it easy to attract new subscribers, send them beautiful email newsletters and see stunning reports on the …

http://theworkben.ch The Workbench is a space where you can get work done and be surrounded by the best kind of coworkers: people creating interesting things. A …

http://oursay.org OurSay.org is an independent organisation started by a team of young people passionate about harnessing the power of social media to …

http://mmmule.com mmMule is a social travel network connecting locals who want stuff with travelers who can deliver it. In return for delivery travelers are …

Inspire9 is a community to support startups, freelancers and creatives in their growth. We share ideas, responsibilities and opportunities. In many instances we …

Sun Seeker provides a FLAT VIEW COMPASS and an AUGMENTED REALITY CAMERA 3-D VIEW showing the solar path, its hour intervals, its winter and summer solstice …

http://moorescloud.com Light by Moore’s Cloud, the light that turns you on. Fifty-two LEDs in two million colors add up to infinite possibilities of pattern and …

http://www.tiliquastudio.com Tiliqua Studio is a creative co-work space with a split personality located in the artistically vibrant suburb of St Peters, …

http://yorkbutterfactory.com The York Butter Factory is the co-working space for Melbourne’s high-potential digital media and web 2.0 entrepreneurs. Established …

Progressions is an app for iPhone, iPod Touch and iPad, which allows you to store, organise and transpose simple chord charts, enabling you to use your device …

http://www.boudist.com Boudist, photos by Sydney Photographer Daniel Boud, Chief Photographer for Time Out Sydney, and published in SPIN, Rolling Stone, NME, …

http://www.ecoffeecard.com.au/ eCoffeeCard, keep all your coffee cards in one secure & convenient app, for iPhone, Android and Blackberry.

http://www.52suburbs.com.au 52 Suburbs, a search for beauty in the Sydney ‘burbs. From September 2009 to October 2010, Louise Hawson explored and photographed …

http://buildar.com buildAR, launched by MOB Labs in 2009, was the world’s first AR Content Management System (AR-CMS). Since then thousands of people from all …

http://www.studiolevant.com Studio Levant, ecology blended with Industrial Chic. Co-working spaces, creative studios, warehouses and green star buildings can …

http://www.electronworkshop.com.au Electron Workshop coworking space. Take the plunge and join a community of people who have the choice of working anywhere, …

http://saasu.com Saasu, because managing your business financials should be rewarding. Our cloud accounting software is a next-generation tool for small to …

http://eatdrinkpaleo.com.au Eat Drink Paleo is an Australian food and lifestyle website published by Irena Macri, a digital professional turned full time …

http://www.buildwithchrome.com Let’s Build. Explore the map, find a plot and start building. – with Lego, right within your browser. Made at Google’s Sydney …

http://ninjablocks.com Ninja Blocks are tiny cloud enabled computers that can sense their environment by receiving input from a variety of sensors & can …

http://fishburners.org Fishburners co-working space and entrepreneurs community. Fishburners is the largest tech co-working space in Australia. We are a …

http://raphaeljs.com Raphaël is a small JavaScript library that should simplify your work with vector graphics on the web, using the SVG W3C Recommendation and …

http://www.shoesofprey.com Shoes Of Prey. Four words: design your perfect shoes. Since 2009, we’ve been making flats, heels, wedges, sandals and more that you …

http://hubmelbourne.com Hub Melbourne is a coworking community that drives innovation through collaboration across diverse sectors, disciplines and generations. …

http://www.protein-one.com/ Protein Studio provides a unique creative collaborative enviroment for designers and developers of multi-disciplinary media in Surry …

http://tweetflight.wearebrightly.com Preflight Nerves, a Twitter-powered film clip by Brightly.

http://www.animallogic.com Animal Logic produces award-winning design, animation and visual effects for the film, television and advertising industries.

http://firemint.com Best known for worldwide hits Flight Control and Real Racingon iPhone and iPad, Firemint was founded in 1999 and developed over 30 games on …

http://visibletweets.com Visible Tweets is a visualisation of Twitter messages designed for display in public spaces.

http://www.atlassian.com Build the World’s Next Great Thing. Our software helps your team create, track, code, and ship products – smarter and faster.

http://www.webdirections.org Web Directions conferences bring together the web industry’s leading experts from around the world to educate and inspire our …